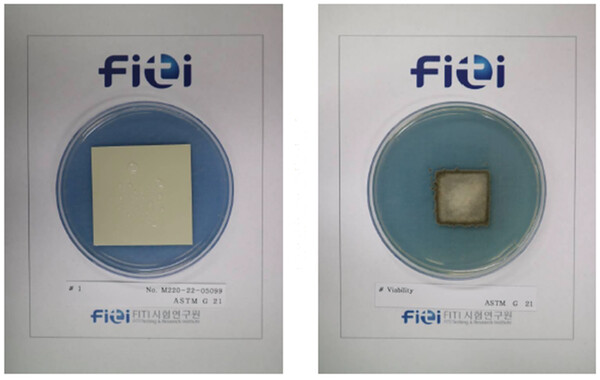

DK동신이 안전한 주거 환경을 만들기 위하여 국내 최초로 항곰팡이 성능을 인증(2022.12.13) 받은 컬러강판을 출시 한다고 밝혔다.
회사측은 국토부 고시 제 2018-697호 건강친화형 주택 건설기준에 준하는 엄격한 기준의 항곰팡이 성능 시험에 합격했다.
항곰팡이 건축자재는 ASTM D 6329 시험 규격의 항곰팡이 저항성 1.0log (CFU)이하, ASTM G 21 시험 규격의 0등급 등 2가지 항목에서 모두 최고 등급을 확보해야 한다.
그동안 항균/항곰팡이 기능성을 선전하는 컬러강판은 많았지만 항곰팡이 성능시험을 통과한 컬러강판 제품은 DK동신이 유일하다.
DK동신측은 사무실과 어린이집, 공장은 물론 거주환경에서부터 창고까지 다양하게 적용이 가능 할 것으로 기대된다며 “현재는 건축 내외장재용 단색컬러강판에 항곰팡이 성능을 확보하였으며, 지속적인 개발을 통하여 건축용 PRINT강판, 가전용 자재에도 적용이 가능한 항곰팡이 강판을 출시할 예정”이라고 밝혔다.
유재혁 기자
yjh@steelnsteel.co.kr

